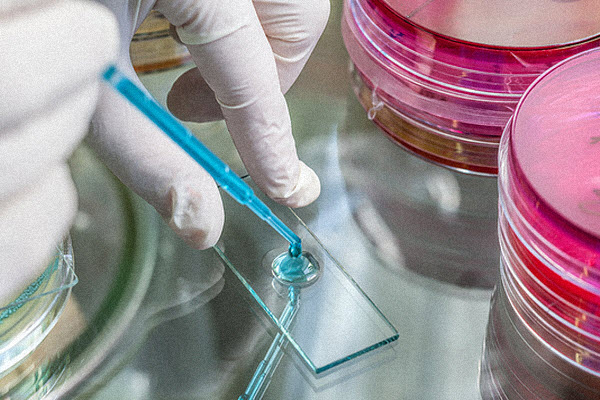

Легионеллез - опасное заразное заболевание, которое легко подцепить на курортах Турции 2026
Обновлено: 15 декабря 2025
Бактерии легионеллы редко существуют в привычных для россиян условиях. Они размножаются только при температуре от +25C до +45C градусов во влажной среде. Поэтому климат Турции просто создан для их жизни.
Многие туристы будут неприятно удивлены тем фактом, что отдыхая в Турции, Вы потенциально становитесь объектом для инфицирования бактериями легионелла. Legionella pneumophila просто обожает жить в сложных системах водоснабжения, которыми оборудованы аквапарки, отели, поликлиники и даже круизные лайнеры. Эта зараза быстро распространяется через ванные комнаты, душевые кабины, различные резервуары с теплой водой, закрытые бассейны для купания, фонтаны и кулеры. Бактерии коллонизируют среду в централизованных системах кондиционирования отелей. Другими словами, где бы вы не находились в отеле на курорте Турции, риск заражения легионеллезом (другое название "болезнь легионеров") очень большой. Он кратно увеличивается при принятии душа или вдыхании воздуха рядом с кондиционером. Бактерия переносится на мельчайших, порой незаметных глазу каплях воды.
Симптомы болезни легионеллёза
Первый симптомы болезни на отдыхе в Турции могут проявляться, как правило, через два дня после контакта с бактериями легионеллы. Они очень похоже на простуду, тривиальную ротовирусную-инфекцию. Итак, вот они: головная боль, общая слабость и озноб. Однако на следующий день температура тела повышается до тридцати девяти градусов, появляется сильнейший кашель, вплоть до выделения крови и, как следствие, рвота. В этот момент многие туристы на курортах Турции ошибочно считают, что их посетила банальная диарея или грипп. Обычные таблетки из "дорожной аптечки туриста" не помогают. Проверенные антибиотики - тоже. Как правило, при продолжении кашля в течение одного дня и высокой температуре нужно безотлагательно обращаться с врачам по медицинской страховке - риск того, что больной подхватил заразу в виде болезни легионеров крайне велик! Если это так, то "отдыхающего" в Турции ждет тяжелейшая форма пневмонии и лечение антибиотиками, которые неизвестны россиянам в обычной практике самолечения. А при продолжении "лечения" в номере отеля, больного могут ожидать более серьезные осложнения - септический шок и дыхательная недостаточность. Надо иметь в виду, что частота летальных исходов для этого заболевания 10%, тогда как при гриппе составляет всего в 0.01%.
Группы риска
Кто же подвергается риску заражения бактериями легионеллы, отдыхая на курортах Турции,
в первую очередь?
1)Люди с ослабленным иммунитетом: любые туристы, которые вынуждены на постоянной
основе принимать лекарства, ослабляющие иммунную систему.
2)Люди, страдающие такими заболеваниями как ВИЧ или СПИД.
3)Люди с любыми хроническими заболеваниями. Например, диабет второго типа может существенно
повысить риск инфицирования. Исследования показали, что сегодня на курорты Турции массово
едут на отдых гипертоники, астматики и люди с заболеваниями сердца.
4)Люди зависимые от курения. Легкие курильщиков повреждены и лучше восприимчивы к
легионелла. К сожалению, процент курящих туристов-россиян неприлично высокий.
5)Люди в возрасте старше 50 лет. В последние годы россияне старшего поколения
массово едут в самые дешевые отели Турции, где игнорирование санитарных норм
обработки может привести к заражению бактериями легионеллы.
Как в Турции можно подхватить болезнь легионера?
Как уже говорилось ранее, наиболее часто болезнь легионеров в Турции можно подхватить в закрытых пространствах отелей - душевых в номерах и закрытых бассейнах, особенно в спа-салонах, где бактерии размножаются быстрее, чем на открытом пространстве. Заражение произойдет тогда, когда жидкость или водный пар попадает в дыхательные пути.
Вот примеры - человек случайно вдыхает водную струю или захлебывается водой при питье из фонтанчика. Особенно опасны замкнутые или централизованные кондиционеры в турецких отелях - там бактерии живут годами и заражают людей через воздух, который прогоняют через системы охлаждения.
В существенно меньшей, почти ничтожной степени, заразиться можно при купании в открытых водоемах, бассейнах и никогда - в море. При правильной санитарной обработке практически невозможно заразиться бактериями легионеллы в ресторане или баре отеля в Турции.
Диагностика и лечение легионеллёза
После поступления в больницу в Турции пациенту с подозрением на легионеллу сделают анализ крови на антитела, которые уже начали невидимую борьбу с бактериями. Также делают т.н. посев, позволяя бактериям развиваться максимально быстро и тем самым идентифицировать их. Есть и другие более современные способы диагностики, например, иммунофлуоресцентный анализ. Многое будет зависеть от квалификации турецких врачей, оснащения поликлиники средствами диагностики. Раннее выявление в организме бактерий легионеллы может помочь назначить правильный план лечения, свести к минимуму периоды излечения и восстановления, избежать серьезных осложнений.
Статистика может привести в шок. В поликлинике умирает каждый четвертый пациент с болезнью легионера. От полученных осложнений гибнет каждый десятый. Даже самостоятельный прием таких антибиотиков, как Левофлоксацин или Ципрофлоксацин, не является гарантией излечения. Многие турецкие больницы замалчивают истинный диагноз, сводя заболевание к обычной пневмонии или переохлаждению. Запомните - перед поездкой в Турцию требуйте у вашего турагента оформленную медицинскую страховку или купите ее на нашем сайте по этой ссылке. И будьте здоровыми!